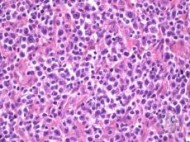

ASH 2014: T-cell lymphomas: a challenge for clinicians
by Thomas R. Collins: Treating patients with T-cell lymphomas is fraught with challenges, requiring new approaches and sharper diagnosis, said Timothy Illidge, MD, PhD, Professor of Targeted Therapy… read more.